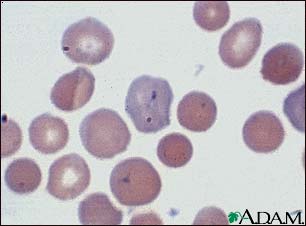
Malaria, microscopic view of cellular parasites

Medical Encyclopedia
Malaria, microscopic view of cellular parasites
Malarial parasites are visible within the red blood cells. They are stained a dark bluish color.
Update Date: 8/10/2008
Updated by: David C. Dugdale, III, MD, Professor of Medicine, Division of General Medicine, Department of Medicine, University of Washington School of Medicine. Also reviewed by David Zieve, MD, MHA, Medical Director, A.D.A.M., Inc.
The information provided herein should not be used during any medical emergency or for the diagnosis or treatment of any medical condition. A licensed physician should be consulted for diagnosis and treatment of any and all medical conditions. Call 911 for all medical emergencies. Links to other sites are provided for information only -- they do not constitute endorsements of those other sites. Copyright 1997-2009, A.D.A.M., Inc. Any duplication or distribution of the information contained herein is strictly prohibited.